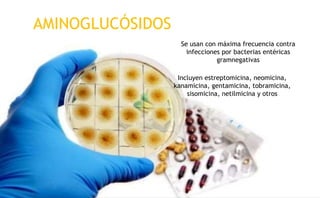

Este documento describe varios aminoglucósidos como la estreptomicina, gentamicina y tobramicina. Se usan para tratar infecciones bacterianas y actúan inhibiendo la síntesis de proteínas bacterianas. Pueden causar efectos adversos como nefrotoxicidad y ototoxicidad. Cada aminoglucósidos tiene un espectro y mecanismo de acción diferente, así como indicaciones y dosis específicas para su uso.